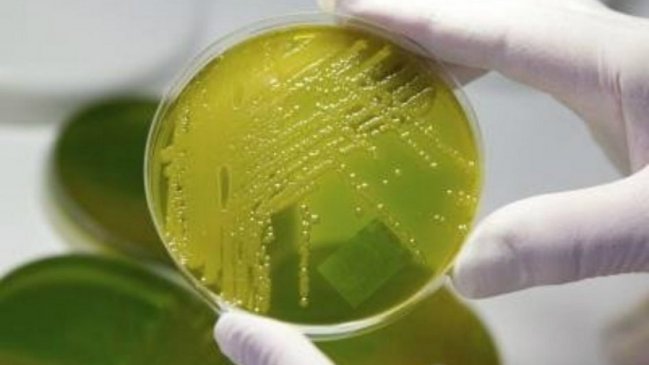
Bacteria en Argentina: Van nueve fallecidos y hay otro caso en estudio

La muerte de un niño en la provincia de Catamarca, en el noroeste de Argentina, y otras dos muertes confirmadas, elevó a nueve el número de fallecidos en los últimos días por la infección de una bacteria, y las autoridades ya estudian otro caso de un menor que falleció en un viaje a Estados Unidos, confirmaron a Efe fuentes oficiales.
En su último informe Boletín de Vigilancia Epidemiológica, la Secretaría de Salud informó de que, desde el 19 de agosto hasta el 14 de septiembre, se han detectado 16 casos de enfermedad por la bacteria Streptococcus pyogenes, y solo uno de ellos, el de un hombre de 40 años ya fallecido, superaba los 8 años de edad.
La mayoría de las infecciones se dieron en la provincia de Buenos Aires (7), la ciudad de Buenos Aires (3) y Catamarca, aunque también hubo brotes en Misiones (noreste), Santa Fe (noroeste de Buenos Aires) y Río Negro (sur), con un caso en cada una de estas provincias.
Además, el pasado domingo falleció un niño de dos años que acudía a un colegio en Olivos, en los alrededores de Buenos Aires, que se encontraba de vacaciones en Estados Unidos con su familia, y que partió al viaje diagnosticado con una angina simple.
Los medios locales apuntaron que era probable que la muerte fuese debida a una infección por la bacteria, algo que todavía no se ha confirmado oficialmente; desde el Ministerio de Salud de la provincia de Buenos Aires aseguraron que el caso se encuentra bajo estudio.